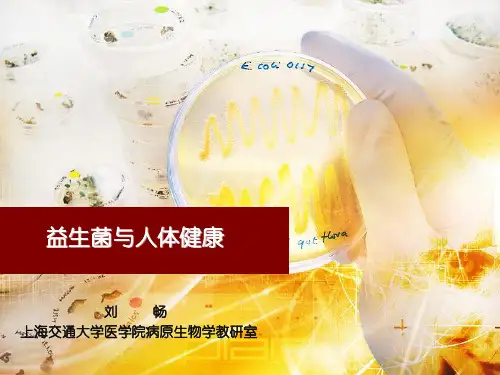

1996年,对益生菌的定义不再强调活菌,
指出: “益生菌剂是含生理活性菌或死细
胞(包含代谢产物与细胞组成),摄取后可
改善粘膜表面菌群或酶的平衡,或刺激机
体的特异性或非特异性免疫力的微生物
制剂”。
目前普遍认为,作为益生菌的细菌应该具备以下条件: 对宿主有益
无毒性作用 无致病作用
能在消化道存活
适应胃酸和胆汁
能在消化道表面定植
能产生有用的酶类和代谢物 在加工和贮存过程中能保持活性 具有良好的感官特性。
3.益生菌的种类
益生菌主要是人类和动物肠道内正常生
理性菌和非肠道菌。
1989年美国食品和药品管理局(FDA)以
及美国饲料监察协会(AAFCO)公布了41 种可用于饲料的安全菌株。
益生菌可粘附于肠粘膜上皮细胞,通过自 身及产生代谢物和抑制物排斥致病菌; 在微环境下保持优势,并与肠道中其他细
菌相互作用,调整菌群间关系,以保证肠道菌
群最佳优势组合,并维持肠道菌群平衡。
益生菌在体内发酵糖类,产生大量乙酸和乳酸,
使环境pH、Eh下降,抑制了致病菌的生长。 益生菌能产生胞外糖苷酶,可降解肠粘膜上皮 细胞的复杂多糖,而这些糖是潜在致病菌和结 合细菌毒素的受体;
Байду номын сангаас
通过酶的作用可以阻止潜在致病菌及其毒素在
肠粘膜上皮细胞的粘附和侵入。
益生菌的代谢作用产生的酸,造成肠道
内的酸性环境,调节和促进肠蠕动,防
止致病菌的定植,维持肠道正常的生理 功能
⑴, ⑵, ⑶
(1)郝生宏,佟建明.益生茵对宿主免疫功能的调节作用【J】.饲料研究,2004,v01.(2):14—15 (2)Merger M。Croitoru K.Infections in the immunopathogenesi S of chronic inflammntory bowel di sease【J】.Sem Immunel,1998,v01.1 0:69—78 (3)Nanji A A,Khettry U,Sadrzadeh S M H.1actobacillus feeding reduces endotoxemiaand severity of experimental alcoholic 1iver(di sea se)【J】.Proc Soc Exp Biol Med,1994,v01.205:243-247